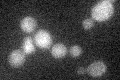
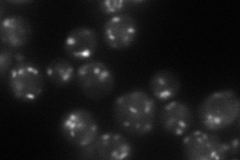
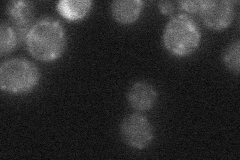

View description
Dipeptidyl aminopeptidase, Golgi integral membrane protein that cleaves on the carboxyl side of repeating -X-Ala- sequences, required for maturation of alpha factor, transcription is induced by a-factor
Localization:
Intensity:
Fold change:
Significance:
-
C’ GFP library in SD
below threshold19.97 -
N' NOP1pr-GFP in SD
punctate61.091 -
N' TEF2pr-mCherry in SD

punctate68.2258 -
N' NATIVEpr-GFP in SD
punctate24.4204 -
N' TEF2pr-VC and Cyto-VN in SD

punctate39.0347 -
C’ GFP library in SD+DTT

cytosolN/AN/ANo -
C’ GFP library in SD+H2O2

cytosolN/AN/ANo -
C’ GFP library in Starvation Media

cytosolN/AN/AYes -
C’ GFP library on the background of Pup2-DaMP

below threshold -
C’ GFP library on the background of CCT mutant

below thresholdN/AN/ANo
